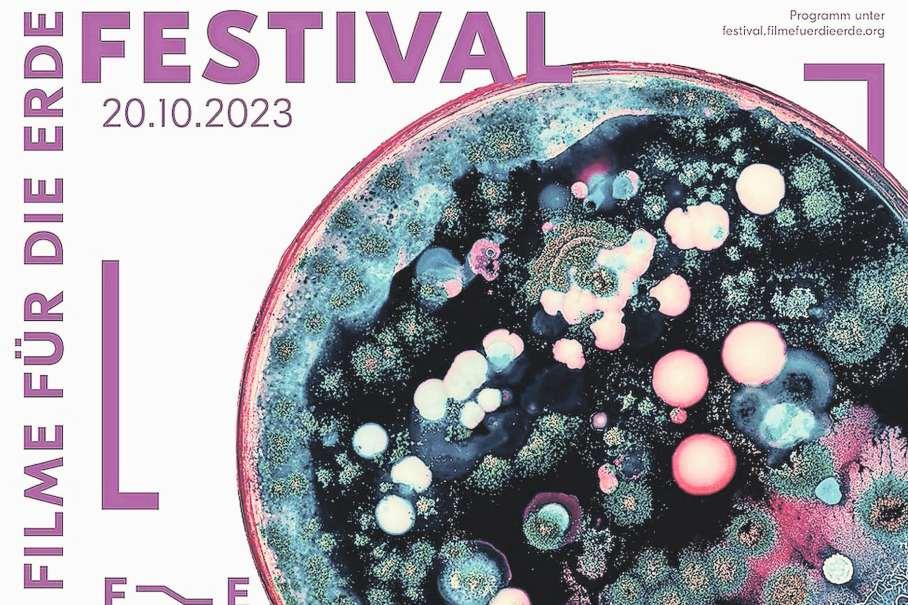

Unabhängige Wochenzeitung für die
Budget 2024

56932 Exemplare Wemf-beglaubigt! Auflagenstärkste Wochenzeitung



 Walter Lipp Der Baarer Gemeindepräsident bekleidet ein weiteres Amt
Walter Lipp Der Baarer Gemeindepräsident bekleidet ein weiteres Amt


Unabhängige Wochenzeitung für die




 Walter Lipp Der Baarer Gemeindepräsident bekleidet ein weiteres Amt
Walter Lipp Der Baarer Gemeindepräsident bekleidet ein weiteres Amt

Stadtzuger Steuerzahler sollen weiterhin in den Genuss eines Rabatts von 2 Prozent auf den bestehenden Steuerfuss von 54 Prozent kommen.
Florian Hofer

Diese teilte Urs Raschle der Vorsteher des Finanzdepartements der Stadt Zug, anlässlich einer Budgetpräsentation vor Medienvertretern mit Trotz rekordhoher Ausgaben rechnet man in der Stadt mit fast 10 Millionen Franken Überschuss im Budget für das
Bei einem Streit in einer Partnerschaft ist ein Mann erheblich verletzt worden Einsatzkräfte der Zuger Polizei haben die Aggressorin festgenommen Die Staatsanwaltschaft des Kantons Zug hat eine Strafuntersuchung eröffnet Was ist passiert? Eine 48-jährige Frau erschien am Samstagmorgen 30 September in einem Verkaufsgeschäft in der Gemeinde Unterägeri und erwähnte dass sie Hilfe für ihren verletzten Partner benötige Die alarmierten Rettungskräfte rückten unverzüglich aus und trafen am Wohnort des Mannes auf einen 48-Jährigen mit Kopf- und Armverletzungen
Die Verletzungen wurden dem Mann bereits am Freitagmorgen 29 September mit einem sogenannten Sappie zugefügt
Grund war ein
Beziehungsstreit
Noch am Einsatzort gab die Meldeerstatterin zu, ihrem Partner die Verletzungen absichtlich zugefügt zu haben Als Motiv für ihre Tat nannte sie einen Streit in der Partnerschaft Sie wurde von den Einsatzkräften der Zuger Polizei festgenommen
Die Staatsanwaltschaft des Kantons Zug hat eine Strafuntersuchung wegen eines versuchten Tötungsdelikts eröffnet
Weiter hat das Zwangsmassnahmengericht auf Antrag der Staatsanwaltschaft die 48-jährige Beschuldigte in Untersuchungshaft gesetzt pd
kommende Jahr Raschle zeigte sich auch für die kommenden
Jahre zuversichtlich: «Die Stadt Zug hat einen gesunden Finanzhaushalt »


104 Millionen Franken gehen in die Töpfe von ZFA und NFA Ausgehend von einem weiteren moderaten Bevölkerungswachstum wie auch der Ansiedlung neuer Unternehmen werde man die Rechnungsergebnisse ausgeglichen gestalten können Dass die Stadt Zug vieles richtig mache zeige sich immer wieder in den Städte- und Gemeinde-Rankings «in welchen die Stadt Zug je-
weils die vordersten Plätze belegt» so Raschle Die Steuereinnahmen bei den natürlichen Personen dürften sich im Jahr 2024 gegenüber dem Budget 2023 um fast 18 Millionen Franken auf 163 Franken erhöhen jene der juristischen Personen um 15 Millionen Franken auf 112 Millionen Franken und die Sondersteuern um 5 Millionen Franken auf 17 Millionen Der budgetierte Fiskalertrag erreicht total 291 Millionen Franken und ist somit 38 Millionen Franken höher als im Budget 2023 Den Erträgen von 390 Millionen Franken stehen
budgetierte Aufwände von 381 Millionen Franken gegenüber Die Nettoinvestitionen ins Verwaltungsvermögen betragen 72 Millionen Franken (Vorjahr 45 Millionen) Getätigt werden sie vor allem durch das Finanzdepartement (für Liegenschaften 16 Millionen für Schulbauten 28 Millionen und für Informatik 1 Million) und durch das Baudepartement (Verkehr und Strassen 20 Millionen, Stadtentwässerung 4 Millionen sowie Anlagen Plätze und Werkhof 3 Millionen) Bis ins Jahr 2033 sollen in Schulbauten 203 Millionen Franken investiert werden Die
Stadt Zug trägt erneut eine höhere Last für den NFA und den ZFA von insgesamt 104 (Vorjahr 92) Millionen Franken
Der NFA 2024 erreicht 24 Millionen und der ZFA 80 Millionen Franken Dies entspricht total einem Betrag von rund 3300 Franken pro Einwohnerin und Einwohner
Das Finanzdepartement hat den Anstoss gegeben, dass der NFA für alle Gemeinden abgeschafft werden soll, dies im Zusammenhang mit der OECD-Mindestbesteuerung von 15 Prozent wodurch der Kanton Zug mit höheren Fiskalerträgen zu rechnen hat
Auf dem Areal der ehemaligen Holzverarbeitungsfabrik Pavatex in Cham sollen Schulräume entstehen Die Gemeinde Cham wählte in einem Wettbewerbsver-
fahren ein Gestaltungsvorschlag aus Dieser zeigt auf, wie eine städtebaulich stimmige Integration in die Nachbarschaft gelingen kann pc Seite 7
Die Konferenz der Finanzchefinnen und -chefs der Zuger Gemeinden hat beschlossen, den Wegfall des NFA und die finanziellen Konsequenzen der 8 Teilrevision des Steuergesetzes im Budget 2024 noch nicht zu berücksichtigen Die Referendumsabstimmung findet im November statt Die jährlichen finanziellen Auswirkungen dieser Änderung auf die Stadt Zug wären rund 20 Millionen Franken tiefere Fiskalerträge was in etwa dem Aufwand für den wegfallenden NFA-Betrag entsprechen würde «Das ist also fast ein Nullsummenspiel» so Raschle



Dreister Überfall bei S-Bahn-Haltestelle
Eine dreiköpfige Gruppe hat in Zug einen Mann bestohlen Die Täter flüchteten mit dem Portemonnaie des Opfers in unterschiedliche Richtungen Der Vorfall ereignete sich am Dienstag 3 Oktober um 17 Uhr im Gebiet Baarer Fussweg, Theiler-/Dammstrasse in Zug Gemäss den Aussagen des 33-jährigen Opfers wurde er von drei ihm unbekannten Männern angesprochen verbal provoziert und anschliessend tätlich angegriffen Mit dem Geldbeutel des Opfers in dem sich rund 500 Franken befanden, entfernte sich die Tätergruppierung Das Opfer begab sich selbstständig in ärztliche Behandlung
Die Zuger Polizei bittet um Mithilfe Wer im Bereich der SBahn-Haltestelle Lindenpark sowie im Gebiet Baarer Fussweg verdächtige Wahrnehmungen gemacht hat, soll sich melden, 041 728 41 41 fh
Glaubens
Christoph Baumann, reformierter Pfarrer, Menzingen
Wir Menschen können ohne
Mythen nicht leben
Das ist eine glasklare Aussage Aristoteles beispielsweise bezeichnete sich als Mythenfreund Mythofilos ist jemand der gerne
Geschichten hört: den täglichen Klatsch, Reiseerzählungen, Kriminalromane, romantische Liebesgeschichten und was es an Geschichten vom Leben alles gibt Mythen sind nichts anderes als Geschichten Früher erklärten sie Sachverhalte, die man noch nicht besser wusste Andererseits bringen sie Wahrheit in die eigene Lebenserfahrung Wahrheit ist viel mehr als blosse exakte Wissenschaft Da brauchen wir nur an die Wahrheit von Leben und Tod zu denken, die häufig hart und grausam ist
Mythen sind in der Lage, diese existenziellen Wahrheiten in unsere Lebenswelt hinein zu erzählen Dabei schaffen sie eine Distanz zur Wahrheit die es ermöglicht, mit Geschichten auch Schicksalsschläge in einer gewissen Entfernung zu halten Dieses Wissen hat mit Glück und Unglück zu tun mit Wahrheit und Irrtum Ein simples Verständnis von «Fortschritt» meint mit der Zeit Mythen ablegen zu können Ein Philosoph nannte dies Striptease, bei dem die Menschen nach und nach mythisch nackt dastehen
Mythonudismus ist nicht wirklich erstrebenswert Dann schon eher sich mit jenen Geschichten umgeben, die von Leben und Tod, von Liebe und Wahrheit sprechen Meinte Gottfried Keller wohl diese menschlichen Identitäten in Geschichten als er «Kleider machen Leute» schrieb?
IMPRESSUM
Mit einem offiziellen Festakt wurde am 29. September die neue Korpsfahne der Zuger Polizei geweiht Die Fahne verbindet
Tradition mit Wandel und symbolisiert Vertrauen, Neutralität und Engagement für Sicherheit und Gerechtigkeit pc
Der Orientierungslauf der OLV Zug in Risch war mit 224 Teilnehmenden ein voller Erfolg.
Der kleine Wald rund um die Erhöhung hinter Risch der sogenannte Chilchberg war am 24 September die Kulisse für diesen spannenden Wettkampf Die engagierten Helfer begannen schon frühmorgens beim Schulhaus Risch mit den Vorbereitungen Der Tag begann mit tiefen Temperaturen Aufsteigende Nebelschwaden über dem Zugersee neben dem idyllischen Dorf gaben ein wunderschönes Bild ab: der erste richtige Herbsttag! Im Verlauf des Tages brach die strahlende Sonne durch den

Dunst und es wurde angenehm warm, was die Veranstaltung noch attraktiver machte Insgesamt konnte in 16 verschiedenen Kategorien welche vier unterschiedlichen Bahnen
entsprachen, gestartet werden: Dieser OL zählte nämlich auch zur Zentralschweizer JugendOL-Meisterschaft (ZJOM) Die Bahnen waren äusserst interessant und abwechslungsreich
19 Senioren im AHV-Alter erlebten vom 18. bis zum 22 September wiederum eine tolle Tenniswoche.

Der traditionelle Samichlaus kommt zu den Kindern nach Hause
stopp
www zugerpresse ch/ eser-service/


Abopreis 175 Franken/Jahr
Vertr eb: Direkt Mai Company AG
INSERATE 041 725 44 56 nserate-zugerpresse@chmed a ch www zugerpresse ch/ nserenten/
Doyen am 2 Giorgios Memorial war mit 83 Jahren Emil Bärlocher vom TC Baar Die TC von Unterägeri, Baar, Zug, Allmend und Hünenberg stellten grosszügig ihre Plätze zur Verfügung und die Clubwirtinnen und -wirte versorgten uns bestens mit Speis und Trank Jeden Tag war ein Spiel zu absolvieren Dies war für die Älteren unter den Teilnehmern auch eine Strapaze, die aber gut gemeistert wurde Wie es zum Giorgios Oldies Cup gehört, wurde nach den Spielen stets gemeinsam gegessen und ausgiebig die Geselligkeit gepflegt Fast zum ersten mal spielte das Wetter nicht mit aber die gute

Laune konnte dies nicht beeinträchtigen Allen Clubwirtinnen und -wirten und ihren Helferinnen und Helfern gilt der grosse Dank von Spielern und Organisator, ebenso den Clubs, welche einmal mehr die Plätze zur Verfügung gestellt haben Dankbar gedenken wir auch Giorgio und Trudy Fattorini sel deren Grosszügigkeit die-
ses Turnier erst ermöglicht haben
Finalspiele
beziehungsweise Ranglisten
MS 65+ R4/R7: 1 Jürg Kunz (4 Siege), 2 Melik Maallem (3 Siege); MS 65+ R7/R9: Mario Conca – Erich Moos: 7:6 6:2; MS 70+ R7/R9: Othmar Limacher – Kurt Schneider: 1:6 6:4 10:1 pd
gelegt was in diesem kleinen Wald eine besondere Herausforderung darstellte
Die Zuger Jugend – es war der 7 ZJOM-Lauf der Saison –schlug sich tapfer: Den ersten Platz erreichte nur Simon van Binsbergen (H16) Nicolas Dinner wurde in derselben Kategorie Dritter Ebenfalls drittplatziert wurde Edris Moosberger (H12) Basil Roos (H10) errang den zweiten Platz
Einige junge Zuger Läufer platzierten sich neben dem Siegerpodest auf dem vierten
Platz: Noemi Spirgi (D10) Mareia Küng (D16) Dario van Binsbergen (H14) und Rafael Spirgi (H12) Alle Resultate können auf folgender Website gefunden werden: www o-l ch Brigitte Di Cicco
Buchtipp
«Koenigs Weg»

Karl Koenig ist ein Mann auf der Höhe der Zeit Er ist fit gepflegt, intelligent; er geht gekonnt um mit den digitalen Gadgets Der Zeitgeist ist sein Freund Und er ist allein Seine «Ich-AG» nennt er Koenigs Korrektionsanstalt Er korrigiert und redigiert beruflich Texte aller Art konzentriert normbewusst geradezu verliebt in die deutsche Sprache Er ist der rührenden Ansicht, wenn er Texte sprachlich verbessere, arbeite er zugleich an seiner Selbstverbesserung
Unverhofft erhält er eine kryptische Kurznachricht von seiner ehemaligen Lebenspartnerin Mirela Kurz darauf begegnet er einer Frau die aussieht wie Mirela und doch ganz anders ist Die Nachricht und die Begegnung werfen ihn aus der Bahn Es beginnt für ihn eine Reise durch Raum und Zeit In einer trostlosen
Besuch von St Nikolaus in den Familien ist ein schöner Brauch, der Eltern und Kinder auf das kommende Weihnachtsfest einstimmen soll Von 3 bis 8 Dezember ist der Samichlaus in der Gemeinde Risch unterwegs Anmeldeformulare sind in der reformierten Kirche Rotkreuz, den katholischen Kirchen Risch und Rotkreuz, der Raiffeisenbank Rotkreuz im Rathaus Dorfmatt und in der Drogerie Schilliger ab Mitte Oktober aufgelegt Anmeldeschluss ist der 12 November Anmeldungen können auch über die PfarreiWebsite www pastoralraumzugersee ch getätigt werden Am Sonntag 3 Dezember um 10 15 Uhr findet in der Pfarrkirche Rotkreuz der traditionelle Familiengottesdienst mit dem SamichlausAuszug statt Familien mit Kindern sind herzlich eingeladen und werden vom Samichlaus beschenkt
Was ist Ihr Anliegen?
Falls Ihr Verein ein bestimmtes (unpolitisches) Anliegen hat, so haben Sie auf 1250 Zeichen inklusive Leerschlägen Platz dafür, dies unseren Lesern zu erzählen Sie können sich gerne bei uns melden Senden Sie uns zum Text noch ein Foto ( JPG-Datei 1 MB) des Autors oder der Autorin sowie die Funktionsbezeichnung an: redaktionzugerpresse@chmedia ch
südosteuropäischen Stadt sieht sich Karl gezwungen die Geschichte seines Lebens und seiner gescheiterten Beziehungen aufzuarbeiten Der Autor Thomas Heimgartner ist in Zug geboren und lebt in Luzern Er unterrichtet Deutsch an der Kantonsschule Zug fh
«Koen gs Weg» von Thomas Heimgartner 150 Se ten pude undp nscher 2023 28 Franken
Nach viereinhalb Jahren übergibt Peter Hausherr (Risch) das Präsidium der Gemeindepräsidentenkonferenz an Walter Lipp.
Florian Hofer
Walter Lipp, Gemeindepräsidentenkonferenz klingt nach einem wichtigen Gremium Wie mächtig ist man als Präsident dieser GPK?
Von Macht kann nicht gesprochen werden Als Präsident habe ich die Aufgabe die Sitzungen zu koordinieren und zu leiten Die vereinbarten Meinungen werden – wenn nötig – durch den Vorsitzenden nach aussen kommuniziert und vertreten Dabei bin ich sehr erfreut und dankbar dass ich auf die Unterstützung meines Sekretärs Reto Herger, Vizegemeindeschreiber, zählen darf
Sie wollen als geeinte Stimme auftreten, etwa wenn es um Verhandlungen mit dem Kanton geht Funktioniert das in der politischen Praxis?
Ja, die Vergangenheit hat gezeigt, dass, wenn man sich unter den Gemeinden einig ist bessere Resultate erzielt werden können Jede Gemeinde kann letztendlich autonom entscheiden Aber der Austausch und die Meinungsbildung unter den Gemeinden sind sehr wichtig und ein wesentlicher Gelingensfaktor
Können Sie ein paar konkrete Beispiele nennen?
Im Moment sind beziehungsweise waren folgende Themen auf dem Tisch: Zug Tourismus (Einführung einer Touristenkarte), Verkehrsfragen (Tunnels in Zug und Unterägeri)
Steuergesetzrevision KlimaCharta Zug Plus Beiträge an regionale und überregionale Grossanlässe IT-Vorhaben SBB-Tageskarte, Ukraine-Krise, Corona-Bewältigung,Totalrevision Beurkundungsgesetz und vieles mehr
Stichwort Finanzausgleich. Die Stadt Zug ist unglücklich über die superhohen Beiträge an den ZFA 80 Millionen Franken zahlt die Stadt nächstes Jahr, Baar zahlt nächstes Jahr 5,4 Millionen Franken und ist zweitgrösster Zahler. Werden solche Themen bei Ihnen im Gremium nicht auch diskutiert?
Diese Themen werden sowohl in der Finanzvorsteherkonferenz wie auch bei uns besprochen Das Ergebnis wird in die Räte getragen und anschliessend der Regierung
eine Rückmeldung gemacht Mit der Regierung finden regelmässige Austauschsitzungen statt
Stichwort Kulturlastenausgleich
Was ist der Stand der Dinge?





Dieser ist leider – aus meiner Sicht – nicht zustande gekommen Der Kanton und die Gemeinden waren sich einig und haben einen guten Vorschlag ausgearbeitet Dieser fand jedoch bei den Kulturorganisationen keinen Anklang Daher ist dieser vom Tisch
Stichwort Steuergesetzrevision

Was ist hier der Stand der Dinge? Über die Revision wird am 26 November abgestimmt Alle Zuger Gemeinden begrüssen die Revision, ebenso die Gemeindepräsidenten-
konferenz und die Finanzvorsteherkonferenz als Gremium Wir freuen uns auf eine grosse Zustimmung seitens der Bevölkerung
Es gäbe ja noch andere Themen, die man in diesem Gremium aufgreifen könne. Der Mangel an bezahlbaren Wohnungen, das Schaffen von Synergien bei der IT (war doch vor ein paar Jahren ein grosses Thema), gemeindeübergreifende Schulraumplanung, Planung von Gewerbeflächen?
Auch solche Themen werden im Gremium besprochen Doch auch hier gilt die Gemeindeautonomie welche es zu respektieren gilt Nicht alle Gemeinden haben die gleichen Herausforderungen und Rahmenbedingungen Aber ein Austausch schadet nie und erweitert das Blickfeld
In der Absicht, die Werte des Kantons Zug und der Schweiz hochzuhalten, das Wohlergehen die Autonomie und die Interessen der Einwohnergemeinden des Kantons Zug zu fördern, den Föderalismus zu leben und zu stärken und im Wissen darum dass Zusammenarbeit und gemeinsam erarbeitete Positionen die Gemeinden stärken, geben sich die Gemeindepräsidentinnen und Gemeindepräsidenten der Zuger Einwohnergemeinden eine Geschäftsordnung Die Gemeindepräsidentenkonferenz nimmt sich insbesondere folgenden Aufgaben an:
• Beratung von Geschäften mit Auswirkungen auf die Gemeinden
• Erarbeitung von gemeinsamen Positionen
Gibt es auch Themen, mit denen Sie nicht vorankommen?
Es gilt zu betonen dass die Gemeindepräsidentenkonferenz keine Entscheidungsbefugnisse hat Der Endentscheid liegt bei der jeweiligen Gemeinde
Daher kann es auch vorkommen dass bei einem Geschäft kontrovers diskutiert wird Aber in der Regel finden wir eine gute und tragbare Lösung Diese tragen wir bei Bedarf nach aussen Viel hört man in der Öffentlichkeit nicht von der GPK – ist eventuell angedacht, mehr zu kommunizieren?
Nein wir äussern uns da wo es uns wichtig erscheint, das heisst, wir sind dann präsent, wenn wir es für notwendig erachten
• Förderung der Zusammenarbeit unter den Gemeinden
• Vertretung der gemeinsamen Interessen der Einwohnergemeinden nach aussen
• Erarbeitung von gemeinsamen Stellungnahmen
• Abgabe von Abstimmungsempfehlungen bei Vorlagen mit besonderem Bezug zu den Zuger Einwohnergemeinden
• Kontaktpflege mit dem Zuger Regierungsrat
• Absprachen betreffend die Einsitznahme in Gremien mit Bezug zu den Gemeinden
• Pflege der Kollegialität Üblicherweise tritt die GPK im Grundsatz zirka sechs Mal pro Jahr zusammen pc

Die bestehende Regenwasserleitung vom Rothusweg bis zum See weist einen sehr schlechten Zustand auf und muss deshalb erneuert werden Von der Gulmstrasse her wurde im Jahr 2009 aufgrund Stark-
Anzeige
regenereignissen der Durchmesser der Leitung bereits vergrössert Jedoch wird vor der Kantonsstrasse die vergrösserte Leitung in die bestehende, im Durchmesser kleinere Leitung geführt Dies ist hydraulisch
nicht optimal und deshalb soll die Regenwasserleitung bis zum See ebenfalls auf neu DN 700 ausgebaut werden Die Leitung erhält eine neue Linienführung entlang der Kantonsstrasse in Richtung
Morgarten und wird beim Grundstück 577 in den See geführt. Durch die neue Linienführung muss nicht zwischen Gebäuden gebaut werden. Die Leitung wird auf einer Länge von 92 Metern neu erstellt und
die Strassenentwässerung an die neue Leitung angeschlossen. Für die Bauarbeiten im Bereich Kantonsstrasse–See wird der Graben mit einer Spundwand erstellt und die Leitung auf Holzpfähle verlegt,
um spätere Setzungen zu vermeiden.
Der Baustart ist Mitte Oktober, die Bauarbeiten dauern ungefähr vier Monate Die Anwohnerschaft wurde entsprechend informiert. pd
Zwei Leser schreiben, wieso aus ihrer Sicht die Rechtsformänderung des Wasser- und Elektrizitätswerks Steinhausen (WESt) in eine AG richtig ist
Im Vorfeld der anstehenden Urnen-Abstimmung über die Rechtsformänderung des Wasser- und Elektrizitätswerks Steinhausen (WESt) sind einige falsche Behauptungen aufgetaucht, die wir beide an dieser Stelle richtigstellen wollen.
Erstens die Behauptung, das WESt werde «am Bürger vorbei verkauft», trifft nicht zu. Die Gemeinde bleibt 100 Pro-
Der Schulstandort Guthirt soll verdichtet werden. Eine Leserin machte sich dazu Gedanken.
Die Mitteilung der Stadt Zug und ein Postulat haben mich hellhörig gemacht Anstelle eines neuen Schulstandorts soll der bisherige Standort Guthirt verdichtet werden Kaum erstaunlich, dass eine Machbarkeitsstudie aufzeigt: Dies ist möglich Schliesslich gibt es auf
zent Eigentümerin der neuen Aktiengesellschaft. Damit ist nicht nur die Grundversorgung gesichert, sondern auch die demokratische Kontrolle EinVerkauf welcher weder geplant noch angedacht ist, müsste in jedem Fall zwingend vors Volk. So steht es in den Bestimmungen und Reglementen, die verbindlich sind.
Verwaltungsrat wird im Auftrag der Einwohner agieren Zweitens der Verwaltungsrat wird nicht «alles in den Händen haben», sondern im Auftrag der Eigentümerin, also der Gemeinde und damit der Steinhauserinnen und Steinhauser agieren. Die Bevölke-
rung kann auf alle Reglemente demokratisch Einfluss nehmen. Und ein professionell aufgestellter Verwaltungsrat kann rasch auf Marktveränderungen reagieren, was im dynamischen Energiemarkt von Vorteil ist.
Mythen vernebeln den Kern der Diskussion Drittens, zur Gewinnausschüttung: Diese wird durch die Aktiengesellschaft nicht kleiner sondern kann sogar gesteigert werden, da der operative Betrieb effizienter wird. Dividenden würden weiterhin dem Gemeindebudget zugutekommen, wie dies schon bei vergleichbaren Überführun-
gen anderer Energieversorger in der Schweiz der Fall ist.
Die Mythen, die jetzt aufgetaucht sind, vernebeln den eigentlichen Kern der Diskussion: die Zukunftsfähigkeit des WESt und die Sicherheit der Grundversorgung für Steinhausen. Ein Status quo würde in einem sich rasch ändernden Markt mehr Risiken als Chancen bieten. Für das WESt und seine Mitarbeiter wäre es zunehmend schwierig, als Gemeindeabteilung im Wettbewerb mit anderen zu bestehen.
Das höchste Ziel des WESt ist und bleibt die Grundversorgung In einer Welt, die sich ständig ändert, wäre Stillstand jedoch der schlechteste aller
Wege Die Umwandlung in eine Aktiengesellschaft ermöglicht es, dieser Verantwortung auch in Zukunft gerecht zu werden und Steinhausen nachhaltig zu stärken.
Informiert und besonnen abstimmen
Wir bitten alle Steinhauserinnen und Steinhauser, bei der anstehenden Abstimmung informiert und besonnen abzustimmen und ein Ja einzuwerfen. Zum Wohle unserer Gemeinde und zur Zukunftsfähigkeit unseres WESt. Reto Schorta, Präsident FDP Steinhausen Gustav Inglin, Mitglied der Betriebskommission WESt
Gerne publizieren wir Ihre Vereinsberichte Achten Sie darauf dass Sie sich kurz halten (zwischen 1500 und 2000 Zeichen inklusive Leerschläge) Bilder müssen als JPEG-Datei in einer Grösse von 0,5 und nicht mehr als 2 MB an uns gemailt werden Ansonsten ist es technisch nicht möglich, die Fotos zu publizieren Schicken Sie zu den Bildern jeweils eine Bildlegende (Personen mit Vorund Nachname von links nach rechts) Geben Sie uns jeweils den Autor des Textes und den Fotografen des Bildes mit vollständigem Namen und Funktion im Verein an Mailen Sie uns den Bericht mit Fotos an: redaktion-zugerpresse@chmedia ch Aufgrund der Vielzahl an Einsendungen können wir leider nicht jede abdrucken red
Ihre Meinung
Möchten Sie einen Artikel in der «Zuger Presse» kommentieren? Dies können Sie gerne tun
jedem Schulareal unbebaute Bereiche Ich möchte aber auf ein paar Punkte hinweisen:
• Guthirt ist das Quartier mit heute schon wenigen öffentlichen Freiräumen, aber auch private Freiräume gibt es – im Gegensatz zu anderen Quartieren – nur in begrenztem Ausmass
• Im Guthirt ist eine massive bauliche Verdichtung vorgesehen wie Tech-Cluster, Hochhaus Pi/GIBZ oder Ahornpark Weitere Projekte sind in der Pipeline zusätzli-
che Freiräume wird es nur in sehr kleinem Ausmass geben Das bedeutet aber auch dass der Nutzungsdruck auf die bestehenden Freiräume nochmals erheblich zunehmen wird
• Der Freiraum der Schule Guthirt ist heute der zentrale Freiraum im Quartier Hier finden Veranstaltungen vom und fürs Quartier statt
• Der Aussenraum der Schulanlage Guthirt ist heute schon übernutzt, das heisst den Schulkindern steht zu
Die vorgeschlagene Steuergesetzänderung im Kanton Zug über die wir am 26 November abstimmen unterstütze ich voll und ganz, da sie vor allem darauf abzielt, den Mittelstand und alle Familien zu entlasten Die Senkung der Vermögenssteuer und die Anpassung des Einkommenssteuertarifs sind weitere positive Schritte die den Mittelstand im Kanton Zug stärken werden Alle Massnahmen tragen dazu bei, dass der Kanton nicht nur für Unternehmen sondern auch für mittelständische Familien und deren Angehörige attraktiv bleibt
Todesfälle
Nicht zuletzt die Erhöhung der Abzüge für Kinderbetreuung ist ein wichtiger Schritt um die Familien gezielt zu entlasten Dies ist besonders angesichts der steigenden Kosten aller Art, darunter auch der hohen Kinderbetreuungskosten von grosser Bedeutung
Die aktuelle finanzielle Lage des Kantons Zug erlaubt diese Steuergesetzänderungen ohne Beeinträchtigung der gewohnten öffentlichen Dienstleistungen
Die zu erwarteten Ertragsüberschüsse in den kommenden Jahren geben uns den finanziellen Spielraum um
Baar 2 Oktober 2023
Dieter Johannes Maria Müller, geboren am 4 November 1932 wohnhaft gewesen an der Bahnmatt 2
Die Beisetzung findet im engsten Familienkreis statt
Baar 30 September 2023
Sonja Larice Oueriemmi-Schneeberger, geboren am 27 Juli
1948, wohnhaft gewesen an der Landhausstrasse 2
Die Beisetzung findet im engsten Familienkreis statt
Cham
27 September 2023
Martha Erni geb Scherer, geboren 1927, wohnhaft gewesen im Pflegezentrum Ennetsee, Rigistrasse 1
Der Abschiedsgottesdienst findet statt am Freitag 20 Oktober um 10 30 Uhr in der kath Kirche Cham Die Urnenbeisetzung findet im engsten Familienkreis statt
diese Entlastungsmassnahmen umzusetzen Es ist in der Tat an der Zeit dass der Staat seinen Bürgerinnen und Bürgern etwas zurückgibt und sicherstellt, dass auch die breite Bevölkerung von der wirtschaftlichen Stärke des Kantons direkt profitiert Die vorgeschlagene Steuergesetzänderung ist jedenfalls ein wichtiger Schritt in die richtige Richtung und verdient die Unterstützung aller Stimmbürgerinnen und Stimmbürger Philip C Brunner, Kantonsrat, Mitglied der vorberatenden Kommission Nationalratskandidat
wenig Freifläche zur Verfügung Mit zusätzlichen Klassen wird das Verhältnis von Schulkindern zu Freiraum noch ungünstiger • Pausenplätze auf dem Dach können nur Notlösung oder ergänzend sein Schulorganisatorisch ist es ungünstig und für (kleinere) Kinder ist der Bezug zum Boden wichtig Fast noch entscheidender ist: Ein solcher Platz kann nicht die gleiche, wichtige Quartierfunktion übernehmen wie ein Platz auf Bodenniveau
(keine zufälligen Begegnungen und so weiter) Aus einer integralen Betrachtung ist die weitere Verdichtung des Schulareals Guthirt sehr fragwürdig Ich bin für Verdichtung, aber sie soll qualitativ gut und mit den nötigen Freiräumen erfolgen So wie es der Stadtrat in seinen Konzepten verspricht Die Stadt Zug soll weiterhin eine hohe Lebensqualität aufweisen – in allen Quartieren Esther Ambühl Tarnowski, GGR SP Stadt Zug
Ihre Meinungsäusserung sollte nicht länger als 2000 Zeichen inklusive Leerzeichen sein Bitte schreiben Sie uns Ihren Vor- und Nachnamen sowie den Wohnort dazu Schicken Sie Ihre Meinungsäusserung an:
redaktion-zugerpresse@chmedia ch
Aufgrund der Vielzahl an Einsendungen können wir leider nicht jede publizieren Wir achten auf eine ausgewogene Auswahl red
Über die Kosten im Wahlkampf macht sich ein Leserbriefschreiber seine Gedanken.
Ganzseitige Inserate Hochglanzbroschüren Gratis-Grillwürste und professionelle Wahlkampfvideos: Politikerinnen und Politiker sind im Moment überall präsent Mindestens 1,2 Millionen Franken wird im Kanton Zug in diesen Wahlen ausgegeben In keinem Kanton steckt mehr Geld im Wahlkampf Umso entscheidender ist es zu wissen
Menzingen 6 Oktober 2023
Anni Maissen-Hürlimann, geboren am 24 Dezember 1933 wohnhaft gewesen an der Luegetenstrasse 13 Abdankung und Bestattung im engsten Kreis: Samstag, 28 Oktober, um 9 30 Uhr Gerne kann man in der Abdankungshalle ab dem 12 Oktober Abschied von Anni nehmen
Unterägeri 2 Oktober 2023
Thomas Iten-Müller, geboren am 19 April 1942 wohnhaft gewesen am Höhenweg 2
Die Trauerfeier findet statt am Freitag 20 Oktober um 10 45 Uhr in der Marienkirche Unterägeri Die Urnenbeisetzung findet im engsten Familienkreis statt
9 Oktober 2023
Oberägeri
Elisabeth Scholl, geboren am 17 Mai 1952, wohnhaft gewesen im Breiten 6 Die Urnenbeisetzung findet im engsten Familienkreis statt
wer denn die Zuger Parteien finanziert In unserer halbdirekten Demokratie müssen wir wissen wer die grossen Geldgeber sind und wie viel eine Wahl- oder Abstimmungskampagne kostet Wenn Bürgerinnen und Bürger kein Vertrauen in die Politik haben liegt dies oft am mangelnden Wissen über die Geldflüsse Die Transparenzinitiative der Jungen Alternativen fordert die Offenlegung der Spenden ab 5000 Franken Das betrifft lediglich 2 Prozent der Spenden die meisten Spenden sind Beträge von zirka 150 Franken Nachdem dies
viele Kantone wie beispielsweise unser Nachbar Schwyz vorgemacht haben ist es an der Zeit dass auch der Kanton Zug diesen Schritt geht Leider lehnt eine Mehrheit mit SVP, FDP, Mitte und GLP im Kantonsrat die Initiative ab und weigert sich der Bevölkerung einen griffigen Gegenvorschlag mit konkreten Zahlen vorzulegen Bleibt zu hoffen, dass bis zur 2 Lesung des Geschäftes im November ein Umdenken stattfindet Luzian Franzini, Co-Präsident Alternativedie Grünen Kanton Zug
3 Oktober 2023
Zug
Walter Senn, geboren am 5 September 1945 wohnhaft gewesen im Seniorenzentrum Mülimatt
Die Beisetzung findet im engsten Familienkreis statt
1 Oktober 2023
Zug
Alejandro Bueno Baigorri, geboren am 18 Februar 1938, wohnhaft gewesen an der Hinterbergstrasse 41
Der Abdankungsgottesdienst findet statt am Dienstag, 31 Oktober, um 15 Uhr in der Kirche St Oswald Die Bestattung fand bereits statt
Zug
19 September 2023
Jean Hangartner-Fischlin, geboren am 22 Juli 1935 wohnhaft gewesen an der Chamerstrasse 72b
Die Urnenbeisetzung hat bereits stattgefunden
«Die weitere Verdichtung in Zug ist sehr fragwürdig»
Eine Premiere im Kanton Zug: gelungenes Speeddating an der Kanti Menzingen
Gerade in unserer technisch und digital geprägten Wissensgesellschaft bieten Mint-Berufe viele nachhaltige und attraktive Möglichkeiten, die Welt mitzugestalten Und gerade junge Frauen – obwohl sie beste Voraussetzungen hätten – entscheiden sich noch zu selten für Mint-Berufe Mint ist die Abkürzung für Mathematik, Informatik, Natur- und Ingenieurwissenschaft sowie Technik
Es gilt, Stereotype jetzt aufzubrechen Über das «Mint-Frauennetzwerk» der Kantonsschule Menzingen soll dies im Kanton Zug zum einen mit dem Experimentiernachmittag «Girls go
Mint» für Primar- und Sekundarschülerinnen, zum andern mit dem «Mint-Speeddating»
für Gymnasiastinnen gelingen Das erste «Mint-Speeddating» im Kanton Zug fand am

28 September statt 35 Schülerinnen der oberen Klassen der Kantonsschule Menzingen
lernten 20 spannende Studentinnen, Forscherinnen und Frauen aus Mint-Berufen persönlich kennen und erhielten
«Durch
Geschichten der Frauen entstanden bereichernde Gespräche.»
M r am Lüde Maturandin
aus erster Hand relevante Informationen zu Natur- und Ingenieurwissenschaften
Dabei tauschten sich die Schülerinnen während vier Minuten auf Augenhöhe mit einer Expertin aus einem bestimmten Mint-Fach aus, hörten von deren Alltag und Projekten und stellten eigene
Die Baarer Schriftstellerin

Theres Roth-Hunkeler setzt in ihrem neuen Roman zum Tabubruch an. Im Mittelpunkt stehen zwei Frauen im Spannungsfeld zwischen Rollenzwang und Selbstfindung.
Die Vernissage des Romans «Damenprogramm» fand kürzlich in der Bibliothek Zug statt Im Publikum sassen auch die Hauptfiguren des Buchs, Anna
Hünenberg
und Ruth Unterschiedlicher könnten die beiden Freundinnen nicht sein Während Anna ihr Leben weitgehend durch Ängste bestimmen lässt lebt Ruth ein eher freimütiges Leben mit zahlreichen Affären Anna hat ihren Mann, den Bruder von Ruth durch eine Demenzerkrankung verloren und quält sich mit Schuldgefühlen weil sie während des Siechtums ihres Mannes nicht die aufopferungsbereite Ehefrau war So stellt sie sich die Frage, ob man neben der Trauer auch erleichtert sein
dürfe über den Tod des nächsten Menschen
Die Seele gleicht einer Libelle, welche die «Damen» inspiriert Anna und Ruth fragen sich, wie man würdevoll altern kann Dabei stellen sie fest, dass sie in ihren Müttern keine Vorbilder hatten da diese sich stets bemühten als «Damen» wahrgenommen zu werden Die eine indem sie Wohltätigkeitsveranstaltungen organisierte, die andere, indem sie sich herausputzte und in Gemeinschaft Eierlikör trank
Fragen Danach ertönte eine Glocke und die Schülerinnen durften einen Stuhl weiterrutschen zum nächsten Date «Der Raum war erfüllt von der Energie und Neugier intelligenter junger Frauen die die Wunder der Mathematik der Naturwissenschaften und des Ingenieurwesens entdeckten Ich wünsche mir, dass es in der ganzen Schweiz mehr Veranstaltungen wie diese geben wird um Fragen zu Mint-Karriereoptionen zu beantworten um Klischees über die Anforderungen an Wissenschaftlerinnen abzubauen und um wirklichzuzeigen,dassWissenschaft für alle da ist», erzählte Paola Luciani, Professorin für Pharmazeutische Technologie an der Universität Bern nach dem Anlass «Durch die vielen individuellen Geschichten der Frauen entstanden bereichernde Gespräche», fand Maturandin Mirjam Lüde pd
Zwischen Melancholie und Selbstironie pendelnd blicken die beiden Frauen auf die Zwiespältigkeit des Alterns: «Der Körper altert stets sichtbarer, wird allmählich zu Gammelfleisch, während die Seele noch immer einer Libelle gleicht» schreibt Anna in einem Brief an Ruth Anna und Ruth weigern sich standhaft altershalber unsichtbar zu werden Aus ihrem Motto «Im Alter noch einmal frech sein» entsteht dann ein «Damenprogramm» der besonderen Art Ingrid Hieronymi
Mit der Umgestaltung der Chamerstrasse wurde der Verkehr durch das Dorfzentrum beruhigt.
Seit Frühling 2023 gilt auf der Chamerstrasse im Dorf Hünenberg Tempo 30. Ein neuer Mehrzweckstreifen in der Mitte der Strasse auf Höhe
Anzeige
Überbauung Maihölzli ermöglicht zudem, die Strasse breitflächig und in zwei Etappen zu überqueren. Diese Umgestaltung der Chamerstrasse hatte die Stimmbevölkerung an der Gemeindeversammlung vom 21. Juni 2021 beschlossen.
Die Gemeinde kommt nach fünf Monaten zum Schluss: Die Verkehrsteilnehmenden haben sich an das neueVerkehrs-
regime gewöhnt. Tempo 30 wird vom motorisierten Verkehr eingehalten und der Verkehrsfluss wurde entsprechend beruhigt. Durch den neuen Mittelstreifen kann die Strasse in zwei Etappen gequert werden. Eine extern durchgeführte Wirkungskontrolle bestätigte dass die Verkehrssicherheit mit der Neugestaltung erhöht wurde «Wie
es bei neuen Verkehrssignalisationen üblich ist konnten im Frühling – und insbesondere als der Deckbelag noch nicht realisiert war – bei Verkehrsteilnehmenden vereinzelt Unsicherheiten betreffend Vortrittsregelungen festgestellt werden» erklärt Theo Kern Leiter der Abteilung Sicherheit und Umwelt «In der Zwischenzeit funktioniert das Miteinan-
der zwischen Fussgängern und Automobilisten »
Weshalb kein Fussgängerstreifen?
Die Verkehrskommission entwickelte zusammen mit Planern sowie Vertretenden von Gewerbe und Dorfbewohnenden die Umgestaltung der Chamerstrasse Neben dem Anliegen der Aufwertung galt
Die Redaktion kontaktieren: Informationen über Inseratepreise: Allgemeine
www zugerpresse unter EVENTS


Baarerstrasse 27, 6300 Zug

ch
der Erhöhung der Verkehrssicherheit auf der Chamerstrasse ein besonderes Augenmerk So entstand der Plan der heutigen Realisierung mit Tempo 30 und einem Mehrzweckstreifen, der eine flächige, in zwei Etappen mögliche Strassenquerung erlaubt – anstelle eines Fussgängerstreifens der die Strassenquerung nur an einer Stelle erlaubt pd
die vielen individuellen
Zugerberg Finanz AG Zug
Wir empfehlen uns für:
Fensterreinigungen Fr. 299.–
Matratzenreinigung Fr. 199.–
Teppichreinigung Fr. 30.– / m²
Umzugsreinigung ab Fr. 699.–
Räumung/Entsorgung Fr. 2.– / kg
Material, Anfahrt und MwSt inbegriffen!
Nomagic Switzerland GmbH Willisau System Operator
Bucher Hydraulics AG Neuheim Gruppenleiter/in Montage Stationär
60% Jobcode 174073



SABAG Luzern AG Gisikon Produktionsmitarbeiter/in Bearbeitungszentrum (Schreiner/in)
LANDI Sempach-Emmen Sempach Station Futtermüller/in/ Anlageführer/in
Caritas Schweiz Zugerberg Betreuer/in Fachbereich Sozialpädagogik 80–100%
Diskrete Abwicklung garantiert! von Guttenberg GmbH
Talstrasse 20, 8001 Zürich Tel. 079 899 00 77 info@von-guttenberg.ch






PILATUS-BAHNEN AG Pilatus Kulm Chef de Réception
W +L. Lustenberger GmbH Luzern Kiosk-/Cafeteria-Mitarbeiter/in
Sie möchten Ihre Stelle ebenfalls hier ausschreiben? – Kontaktieren Sie uns unter +41414295999 oder via info@zentraljob ch
JOBMAIL
Erhalten Sie kostenlos alle neuen für Sie passenden Stellenangebote per E-Mail! zentraljob ch/jobmail
Die FFZ ist auf dem gesamten Zugersee bestmöglich gerüstet. Das Rettungsboot Kolin 10 wurde am letzten Freitag auf den Namen «Cerasus» getauft
Hans-Peter Schweizer
Die Freiwillige Feuerwehr der Stadt Zug ist für die Seerettung auf dem ganzen Zugersee verantwortlich Weil der Zeitwert des alten Seerettungsbootes überschritten war und die Reparatur- und Unterhaltskosten der «Magellan» massiv zugenommen hatten, wurde eine interne Arbeitsgruppe unter der Leitung von Markus Müller beauftragt die Grundlagen für eine Ersatzbeschaffung zu erarbeiten Das neue Boot ist seit dem Frühjahr – allerdings noch ohne Namen – in Betrieb

Ein mit Hightech ausgerüstetes Arbeitsgerät
Daniel Jauch Kommandant der FFZ betonte in seiner begeisterten Begrüssungsrede die Vorteile des neuen Arbeitsbootes: «Mit dem neuen Rettungsboot hat die FFZ ein modernes und zeitgemässes Arbeitsboot erhalten » Das von der Firma Rütenen Marina AG aus Beckenried ausgebaute Boot verfügt über eine grosszügige ebene Arbeitsfläche im Bug samt einer hydraulischen Bugklappe Eine fix verbaute Löschpumpe mit Wasserwerfer oder Strahlrohr ermöglicht Löscheinsätze auf dem See wie auch in Ufernähe Auf dem Mast ist eine Kamera für Wärmebild- und Restlicht-Aufnahmen eingebaut welche bei Sucheinsät-
zen wertvolle Dienste leisten wird Der Heckbereich ist zudem mit einer Schleppvorrichtung bestückt – zur sicheren Bergung von in Seenot geratenen Wasserfahrzeugen Das Boot Cerasus ist im Bootshaus in der Zuger Unteraltstadt stationiert Gleichenorts befindet sich auch die Basis «Formation Seedienste» der FFZ, unter Führung von Christian Weber Aus den Ausführungen von Stadträtin Barbara Gysel Vorsteherin Departement Soziales Umwelt und Sicherheit (SUS) war zu vernehmen dass der Seerettungsdienst für technische Hilfeleistungen
Zum zehnten Mal bringt der Rabe Abraxas einen bunten Strauss an Geschichten nach Zug
Poetische Sprachspielereien, Nachwuchsdetektive,ein Monstersheriff oder Cowboy Klaus im Wilden Westen oder auch Geschichten die mit Geräuschen Stimmen und Musik zum Leben erweckt werden: All das bringt der Rabe Abraxas zum zehnten Mal nach Zug Am Zentralschweizer Kinder- und Jugendliteratur-Festival sind alle eingeladen, in eine Welt der Buchstaben einzutauchen etwas auszuprobieren und mitzumachen
Zum Auftakt am Samstag verzaubert Lorenz Pauli die ganze Familie mit poetischen Sprachspielereien. Bei Christian Seltmann gibt es etwas auf die Ohren, Annette Gröbly zeigt, wie aus Alltagsmaterialien echte Wunderwerke entstehen, und Gina Mayer entführt das Publikum mit in die Stadt der bösen Tiere Am Sonntag geht es mit Michael Petrowitz zu den Ninjas und danach zeigt er, wie man selbst spannende Geschichten schreibt.
Mit Andrea Karimé fliegt das Publikum auf einem kunterbunten Geschichtenteppich

Um die steigenden Preise unter Kontrolle zu bekommen erhöhten die Zentralbanken der wichtigsten Wirtschaftsregionen in den vergangenen Monaten ihre Leitzinsen im Rekordtempo Nach einer langen Phase der Null- und Negativzinsen sprangen die Leitzinsen in den USA förmlich auf 5 5 Prozent im Euroraum zog die EZB auf
4 5 Prozent nach und in der Schweiz beliess die SNB zuletzt den Referenzzins bei
oder Such- und Rettungseinsätze jährlich 25- bis 35-mal
mer- oder zur Winterzeit etwa die Waage Gysel weiter: «Einsätze der Seerettung sind damit ein wesentlicher Aufgabenbereich der FFZ und in der Statistik nach Einsatzarten weit vorne »
Eingaben hat der Vorschlag von Anja Weibel aus Zäziwil BE «Cerasus» – lateinisch für Kirsche oder Kirschbaum – die Jury überzeugt
DanielJauch Kommandant der FFZ
beansprucht wird Dabei halten sich die Einsätze zur Som-
Auch für die englischsprachigen Bücherfans wird ein abwechslungsreiches Programm angeboten
Verleihung des
6 Baarer Raben Alle zwei Jahre vergibt der Kinder- und Jugendliteraturverein Abraxas zusammen mit der Gemeinde Baar einen Förderpreis für die beste deutschsprachige Nachwuchsautorin oder den besten Nachwuchsautor 2023 wurde zum sechsten Mal der Baarer Rabe durch eine namhafte Jury aus Fachpersonen der Kinder- und Jugendliteraturbranche vergeben Die Gewinnerin ist die Bernerin Sandra Rutschi mit der Geschichte «Leonie lernt fliegen» Zum Abschluss des Festivals findet am Sonntagnachmittag die Preisverleihung mit einer szenischen Lesung statt
Eine Reservation wird empfohlen
Insgesamt 24 Veranstaltungen sorgen am Samstag, 4. November und Sonntag, 5. November,auf dem Burgbachareal in Zug für viel Abwechslung
Der Eintritt ist frei Platzkarten für alle Veranstaltungen können zwischen dem 16 und 29 Oktober unter www eveno com/abraxas23 reserviert werden pd
Namensgeber wurde per Instagram gesucht Auf der Suche nach einem Namen für das Rettungsboot hatte die FFZ Ende April auf Instagram aufgerufen kreative Namensvorschläge einzureichen Der Name sollte einen direkten Bezug zum Zugersee aufweisen Aus den unzähligen
In seiner lehrreichen wie auch humorvollen Ansprache brachte es Rémy Frick auf den Punkt: «Was für ein trefflicher Name für ein Boot welches seinen Dienst von nun an offiziell auf dem schmucken Zugersee versehen wird Wer weiss: Vielleicht gibt es für den Schiffbrüchigen dereinst einen Schluck aus der Kirschflasche – zum Aufwärmen und als Tröster für die gerettete aber dennoch verängstigte Seele »
Mit einem Siegerprojekt wird nun das PavatexAreal weitergeplant.
Um genügend Unterrichtsräumlichkeiten für die wachsende Anzahl von Chamer Schülerinnen und Schülern zu schaffen, ist als mittelfristige Massnahme auf dem Pavatex-Areal ein neuer Schulstandort vorgesehen Dieser wird Kapazitäten für zwei Klassenzüge umfassen inklusive Räume für die Modulare Tagesschule sowie eine Dreifachturnhalle Ein Klassenzug entspricht zwei Kindergarten- sechs Primarschulklassen und einer Sonderklasse Für den Bau der neuen Schule kann die Gemeinde das Land von der Grundstückeigentümerin Cham Group erwerben Aus Sicht der Chamer Gemeinderätin Brigitte Wenzin Widmer, Vorsteherin Bildung eine wichtige Notwendigkeit: «Das Pavatex-Areal ist der ideale Standort an dem wir einen Teil des künftigen Bedarfs an Schulräumen mitten in einem Gebiet mit einer starken, innovativen Dynamik und hohem Potenzial decken können »
Das Beurteilungsgremium hat sich entschieden
In einem Konkurrenzverfahren gemeinsam mit der Cham
Group hat die Einwohnergemeinde vier Planungsteams beauftragt Studien für einen städtebaulichen Entwurf über das ganze Areal zu erarbeiten Ziel des Studienauftrags war eine hochwertige städtebauliche Lösung mit einem grossen Anteil unbebauter Freiflächen Die beiden Auftraggeberinnen wollten ein breit diskutiertes und akzeptiertes Konzept entwickeln das sich sowohl in die ganze Gemeinde als auch in die unmittelbare Umgebung gut einfügt Das Beurteilungsgremium hat entschieden das Projekt der Arbeitsgemeinschaft der Architekturbüros Ramser Schmid mit Enzmann Fischer sowie Skala Landschaftsarchitektur für die

Weiterbearbeitung zu empfehlen Das Projekt schlägt vor das entstehende Quartier auf dem Pavatex-Areal ausgehend der geplanten Freiraumstruktur auf dem benachbarten PapieriAreal weiterzubauen Parallel zur Knonauerstrasse soll eine Quartierachse entstehen Diese verbindet die geplante Musikschule Vereins- und Freizeitzentrum mit dem Schulhaus Pavatex im Norden des Areals Durchs Areal gelangen die Kinder über kinderfreundliche, zur Bewegung einladende und autofreie Schulwege zur Schule Ein Velo- und Fussweg mit verschiedenen Spiel- und Sportmöglichkeiten führt zum Naherholungsgebiet Lorzenpark pd
1,75 Prozent Während Tagesgeldsätze in Euro und US-Dollar in Sphären vorstossen die seit über 10 Jahren nicht mehr gesehen wurden müssen eidgenössische Sparer sich weiter in Geduld und Verzicht üben Erst seit kurzem übersteigen die Sparzinsen bei Raiffeisen, Postfinance und Kantonalbanken die Marke von 1 Prozent Und die UBS bietet für neue Kunden sogar Traumkonditionen von bis zu 1,75 Prozent Diese Konditionen sind weit davon entfernt, als «sexy» bezeichnet zu werden und doch stehen sie im scharfen Kontrast zu den noch vor kurzem verbreiteten Strafzinsen auf Kontoeinlagen Ein Blick über die Schweizer Alpen hinaus könnte sich lohnen: Das Zinsniveau im Euro- und Dollarraum liegt deutlich höher und dazu kommt der starke Franken Es war fast noch nie so attraktiv Franken in Euro und Dollar zu tauschen Die gestiegenen Zinsen machen Zinspapiere für den Anleger attraktiver Im Umkehrschluss bläst den Aktienmärkten hierdurch der Wind ins Gesicht In den letzten Wochen gaben Schweizer Aktien gemessen am SMI ihre gesamten Zugewinne des Jahres 2023 ab Einige in der Zentralschweiz beheimatete Unternehmen wie Partners Group Zuger Kantonalbank und Emmi heben sich bislang positiv ab Auch ist dem Aktienkurs der UBS die Übernahme der Credit Suisse zum Schnäppchenpreis bislang gut bekommen, doch wird auch hier der Wind rauer Ähnlich sieht es bei Gold aus Hohe Zinsen auf dem Sparkonto trüben dessen Glanz Doch Vorsicht wer hier die Flinte ins Korn werfen möchte: Das Metall ist ein Krisengewinner, und neben Rezessionsängsten und geopolitischen Querschlägern währt die Zeit vergleichsweise hoher Zinsen möglicherweise kürzer als man denkt Der Autor ist Wirtschaftsbuchautor er leitet die Vermögensverwaltung von Asset Management Switzerland AG in Zug und lehrt Wirtschaft und Finanzen an verschiedenen Hochschulen in Europa darunter auch an der Hochschule Luzern (HSLU).
«Mit dem neuen Rettungsboot hat die FFZ ein modernes und zeitgemässes Arbeitsboot erhalten.»Die Teilnehmenden bei der Bootstaufe (von links): Hugo Halter Barbara Gysel (Stadträtin), Daniel Stadlin, Anja Weibel Christian Weber Daniel Jauch, Samuel Schmid und Markus Müller B ld Hans-Peter Schwe zer Die Projektverantwortlichen (von links): Lukas Fehr, stellvertretender CEO Cham Group, Daniel Meister Projektleiter, Geme nderat Drin Alaj, Thomas Aebischer, CEO Cham Group, und Philipp Fischer, Enzmann Fischer Architekten Bi d pd



Schnarchen kann harmlos sein Es kann aber auch ein Hinweis auf Schlafapnoe sein.
Auch für den Schnarcher selbst, der von dem lauten Getöse meist nichts mitbekommt, kann Schnarchen zur Belastung werden. Lautes und unregelmäßiges Schnarchen kann nämlich auf eine Schlafapnoe hinweisen Eine Krankheit, bei der im Schlaf für einige Sekunden die Atmung aussetzt In schwerwiegenden Fällen denkt der Körper 30-mal in der Stunde, er ersticke. Dieses laute, unregelmässige Schnarchen wird oft unterschätzt Ein Fehler, schliesslich haben Schlafapnoe-Patienten ein zehn bis zwölf Mal erhöhtes Schlaganfallrisiko und leiden unter Tagesmüdigkeit.
Ruhestörendes Schnarchen und leichtbis mittelgradige Schlafapnoe können mit
Zahnschienen, auch Protrusionsschienen genannt, behandelt werden. Diese werden basierend auf Ihren individuellen, digitalen Gebissabdrücken hergestellt. Die Zahnschienen halten Unterkiefer, Zunge und Gaumensegel während des Schlafes vorn. So bleibt der Rachenraum weit geöffnet, die schlaffen Rachenmuskeln werden stabilisiert und die Lunge wird wieder mit genügend Luft versorgt, um das Blut ausreichend mit Sauerstoff zu sättigen.
Das TEAM 15 – Praxis für Zahnmedizin berät Sie gerne in Zusammenarbeit mit Ihrem Hals-Nasen-Ohrenarzt, damit Sie nachts wieder ruhiger und erholsamer schlafen können.

erholsamenEndlichwieder Schlaf –mitSchnarchschienen von TEAM15
Unsere neuen Öffnungszeiten:






Mo und Freitag 8-17.30 Uhr

Di bis Donnerstag 8-18.30 Uhr





Die Zuger Einkaufs-Allee Metalli wurde zum Schauplatz einer charmanten «Catwalk-Show der Herzen»
Die unvergleichliche Show die liebevoll als «Catwalk der Herzen» bezeichnet wird hebt sich durch ihre warme und sympathische Atmosphäre von anderen Shows ab Die Metalli hat wieder einmal bewiesen, dass Mode für alle zugänglich und vielfältig sein sollte Mehr als 120 Personen aller Altersgruppen haben sich beworben 22 Talente wurden aufgrund ihrer authentischen Ausstrahlung ausgewählt
Viel Applaus für die grossen und kleinen Models
Die frischgebackenen Models haben in den letzten Wochen ein professionelles Laufund Choreografie-Training
Marktplatz
Der «Marktplatz» ist eine sporadisch publizierte PRPlattform der «Zuger Presse» für Firmen aus dem Kanton Zug und Umgebung Falls auch Sie einen Beitrag beisteuern wollen, kontaktieren Sie uns bitte per Mail: inserate-zugerpresse@chmedia ch oder über 041 725 44 56 Ihr «Schaufenster» können Sie auch im Internet buchen: www zugerpresse ch red
genossen und konnten somit die Herbst- und Winterkollektionen mit einer Mischung aus Professionalität und Authentizität präsentieren Egal ob es die Kids-Gruppe mit der kleinen bezaubernden Mira war oder die anderen sympathischen Gruppen – je-
der Moment wurde von Begeisterung und Applaus begleitet
«Eine unvergleichliche Nähe und Herzlichkeit»
TV-Ikone und Beauty-Spezialist Jörg Kressig moderierte die Show und stellte die The-












men Nachhaltigkeit und Gemeinschaft in den Mittelpunkt Sein Resümee: «Die Einbindung echter Kundinnen und Kunden macht diese Show besonders authentisch und verleiht ihr eine unvergleichliche Nähe und Herzlichkeit » Die Begeisterung
war nicht nur auf dem Laufsteg zu spüren, sondern auch im Publikum und bei den Organisatoren
Die Gäste die frischgebackenen Models und die teilnehmenden Labels teilten die Freude und die Aufregung Diese einzigartige Show, wel-
che die Community und die Vielfalt in den Vordergrund stellt, lässt die Zuger Einkaufs-Allee Metalli in einem sympathischen Licht erstrahlen und die Vorfreude auf die nächsten nachhaltigen und integrativen Projekte wachsen pd
Die Zuger Kantonalbank ermöglicht ihrer Kundschaft als erste Kantonalbank den einfachen Handel und die sichere Verwahrung der gängigsten Kryptowährungen
WWZ AG

Nach zweijähriger Bauzeit hat WWZ vor wenigen Tagen den ersten
Abschnitt des Wärmeverbunds Ennetsee erfolgreich in Betrieb genommen: die Transportleitung zwischen
Perlen und Rotkreuz Damit werden nun die ersten rund
40 in der Gemeinde RischRotkreuz angeschlossenen Liegenschaften mit CO2-neutraler Abwärme für Heizung und Warmwasser versorgt –rechtzeitig zur Heizperiode 2023/24 WWZ arbeitet mit Hochdruck an der Verdichtung und dem weiteren Ausbau des Wärmeverbunds, um bald auch Holzhäusern, Hünenberg See und Cham mit regionaler Wärmeenergie zu

versorgen Ganz unspektakulär aber nichts weniger als ein Meilenstein für die regionale Energie- und Klimazukunft: Mit dem schlichten Aufdrehen eines handtellergrossen Schiebers in der Energiezentrale Schöngrund in Rotkreuz nahm WWZ vor wenigen Tagen den Wärmeverbund Ennetsee in Betrieb Ab jetzt fliesst Abwärme von der Kehrichtverbrennungsanlage (KVA) Renergia Perlen ins Verteilnetz Rotkreuz und versorgt erste Liegenschaften in der Gemeinde mit regionaler umweltfreundlicher und CO2-neutraler Energie für Heizung und Warmwasser pd
Mehr dazu auf wwz ch
Ab sofort können Kundinnen und Kunden der Zuger Kantonalbank in Kryptowährungen wie Bitcoin Ethereum XRP Litecoin Polygon und Uniswap investieren Der Kauf der Handel und die Verwahrung der digitalen Vermögenswerte erfolgen einfach und bequem über das E-Banking oder
Mobile Banking der Bank und werden gegen US-Dollar abgewickelt Der Handel findet von Montag bis Freitag von 1 30 bis 22 Uhr statt Selbstverständlich steht das Angebot auch neuen Kundinnen und Kunden der Bank offen «Wir beobachten, dass die steigende Nachfrage nach Kryptowährungen schon
lange nicht mehr nur von professionellen Marktteilnehmern kommt Wir freuen uns deshalb sehr dass wir unseren Kundinnen und Kunden ab sofort einen einfachen komfortablen und zugleich sicheren Zugang zu diesen Märkten ermöglichen können, ohne dass sie ihr gewohntes Banking-
Umfeld verlassen müssen In Zusammenarbeit mit unseren Partnern haben wir eine fortschrittliche Infrastruktur aufgebaut mit der wir Anlegerinnen und Anlegern eine zusätzliche Diversifikationsmöglichkeit anbieten können», sagt Hanspeter Rhyner, CEO der Zuger Kantonalbank pd
Der Umwelt zuliebe: Seit 2019 produziert eine Photovoltaikanlage auf dem Flachdach des Neubaus von Möbel Schaller Solarstrom Sie hat eine Leistung von 100 kWp (Kilowatt-Peak) Seit 2021 ist ferner ein Speicher mit einer Kapazität von 65 Kilowattstunden im Einsatz Damit lässt sich die überschüssige Energie speichern und später verwenden

Leistung entspricht dem Bedarf von 45 Einfamilienhäusern Vor kurzem wurde zudem im Rahmen einer energetischen Sanierung die Isolation des Schrägdaches auf dem Hauptgebäude erneuert. Gleichzeitig wurde dort eine weitere Pho-
tovoltaikanlage installiert Nun liefert das hauseigene Kraftwerk 250 kWp – es sind also zusätzliche 150 hinzugekommen Die neue Leistung entspricht dem Bedarf von rund 45 Einfamilienhäusern Der interne Verbrauch von 100 000 Kilowattstunden ist bei weitem gedeckt und Möbel Schaller kann einen beträchtlichen Teil des produzierten Stroms ins öffentliche Netz einspeisen All das zeigt: Nachhaltigkeit ist im Familienunternehmen Möbel Schaller aus Geuensee nicht bloss eine modische Worthülse sondern wird tatsächlich gelebt pd Besuchen Sie uns auf: www moebelscha er ch
Möchten Sie ein neues Produkt lancieren die Neueröffnung Ihrer Firma bekanntmachen oder auf einen speziellen Firmenevent hinweisen? Oder haben Sie sonst eine Mitteilung an Ihre Kunden?
Die Rubrik Schaufenster hat ihren Platz jeweils am Dienstag in der «Zuger Presse» sowie im «Zugerbieter» und wird in sämtliche Haushalte im Kanton Zug in einer Auflage von mehr als 55 000 Exemplaren verteilt
Buchen Sie Ihren Eintrag unter www.zugerpresse.ch























Veranstaltungskalender
SEMINAR VERGEBUNGSSEMINAR Am Donnerstag, 19 Oktober, findet am Falkenweg 10 in Baar ein Vergebungsseminar statt Lernen S e zu vergeben –Ihrem inneren Frieden und Ihrer Gesundhe t zuliebe, 7 Abende, 19 10 bis 30 11 23 www llg ch
CHILBI IN OBERÄGERI
Am Samstag und Sonntag, 14 und 15 Oktober, m Areal Muk/Bachweg: Luna Park Chilbibe zen Markt Beg nn ist am Samstag um 14 Uhr am Sonntag um 10 Uhr Chilbigottesd enst ist am Sonntag um 10 Uhr Musik: Dorfspatzen Oberägeri

THEATER KOMÖDIE IN MENZINGEN
Wenn die Alten flügge werden Komödie m Zentrum Schützenmatt in Menz ngen Premiere am Freitag 20 Oktober um
20 Uhr Weitere Aufführungen bis zum 28 Oktober
Infos: www theatermenzingen ch
KONZERT «MINI SCHWIIZ»
Am Samstag 21 Oktober findet ein
Konzert unter dem Titel «M n Schw iz» n der Aegerihalle in Unteräger statt Es sp elt die Feldmusik Unteräger es s ngen die Männerchöre Baar und Unterägeri Beg nn ist um 20 Uhr Türöffnung um 18 Uhr, Eintritt frei, Ko lekte
Anlässe in der Region
Gegen einen Unkostenbeitrag von 20 Franken veröffentlichen wir Ihren Event (bis zu sechs Zeilen) auf dieser Seite Für 175 Franken können Sie ein
Premium-Event (siehe unten) mit Bild und 20 Zeilen Text buchen
Buchen Sie Ihren Eintrag online unter www zugerpresse ch red
Die besten Umweltdokus anschauen: Am 20 Oktober findet das 13. Filmefür-die-Erde-Festival in Zug statt.
Dieses Jahr dreht sich am Filme-für-die-Erde-Festival alles um Kreislaufwirtschaft Die Filmauswahl ermöglicht einerseits Einblick in atemberaubende Naturlandschaften zeigt andererseits das Engagement von Menschen, die sich unermüdlich für geschlossene Material- und Energiekreisläufe einsetzen Die Protagonistinnen und Protagonisten im Film «Going Circular» lüften beispielsweise das Geheimnis des
Konzepts der Kreislaufwirtschaft – ein Wirtschaftssystem das die planetaren Ressourcen schont In «Holy Shit» leben die Akteurinnen und Akteure die Sanitärwende und erzeugen mit eigenen Kläranlagen Dünger und Strom
«Holy Shit» – eine Schweizer Filmpremiere Was geschieht mit unserer Nahrung nachdem sie verdaut und ausgeschieden ist? Sind Fäkalien Abfall oder eine Ressource? Können wir mit Exkrementen die Welt retten? Auf der Suche nach Antworten reist Regisseur Rubén Abruña durch die Welt und folgt der Spur der menschlichen Fäkalien von den Pariser Abwasserkanälen bis zu
einer der grössten Kläranlagen der Welt in Chicago In «Holy Shit» zeigen Slum-Bewohnende aus Uganda wie sie aus Fäkalien Kompost herstellen In Hamburg und Genf besucht der Regisseur Wohngebiete, die mit eigenen Kläranlagen Strom und Dünger erzeugen
«Going Circular» – das Konzept der Kreislaufwirtschaft
Wie wäre es in einer Zukunft zu leben in der die Menschheit nicht einfach überlebt, sondern aufblüht, indem sie die planetarischen Grenzen respektiert und die bisherige Welt umgestaltet? «Going Circular» lüftet die Geheimnisse des Konzepts der Kreislaufwirtschaft – ein Wirtschaftssystem das Abfall
In seinem Programm begibt sich der Science-Slammer Geschichtenstaubsauger und Archivjunkie Benedikt Meyer auf eine Tour d Horizon durch die absurden Seiten der Schweizer Geschichte Von den Helden unserer Jugend über die grenzenlose Liebe zu Grenzen bis hin zu Schönheitsoperationen für tote Hunde Ein Potpourri vergessener Anekdoten zwischen Augenzwinkern und historischem Ernst Mit seinem Geschichtskabarett hat Meyer ein neues Genre erfunden – und schöpft dabei aus der randvollen Schatztruhe vergangener Irrtümer und Missgeschicke Blöderweise gibt es Historiker pd Theater im Burgbachke er Zug Fre tag, 13 Oktober, 20 Uhr www burgbachkeller ch
TOX INFO 145
Kostenlose mediz nische Beratung bei Vergiftungsfällen
RETTUNGSDIENST 144
FEUERWEHR 118
POLIZEI 117
BERATUNG FÜR KINDER
vermeidet und die Ressourcen des Planeten schont Der Dokumentarfilm zeigt konkrete Lösungen auf mit denen einzelne Personen und ganze Gemeinden überall auf der Welt zur Kreislaufwirtschaft übergehen können
Über das Filme-für-die-Erde-Festival
Bereits zum 13 Mal findet das Filme-für-die-Erde-Festival statt Während mehrerer Tage zeigt es die besten Umweltdokus des Jahres Das Festival bietet Filmvorführungen für Schülerinnen und Schüler Erwachsene und Familien Filme für die Erde machen dem Publikum wichtige Umwelt- und Klimathemen zugänglich pd
UND JUGENDLICHE 147 Kostenlose Unterstützung für unge Menschen bei kleinen oder grossen Sorgen Probleme oder Fragen Ein Angebot der Pro Juventute
DARGEBOTENE HAND 143
Kostenloses Schweizer Sorgentelefon
BERATUNG FÜR ELTERN 0848 35 45 55 Hilfe und Beratung für Eltern bei erz eherischen Belastungssituationen Konflikten Krisen oder Gewalt
SUCHTBERATUNG KANTON ZUG 041 728 39 39 Montag bis Freitag von 8 bis 12 Uhr und 13 30 bis 17 Uhr
ZUG APOTHEKE
Bahnhofplatz, Zug, 041 720 10 00 Montag bis Freitag: 7 bis 21 Uhr Samstag Sonntag und Feiertage: 8 bis 20 Uhr
Vergeben ist lernbar
Lernen Sie zu vergeben –
Ihrem inneren Frieden und Ihrer Gesundheit zuliebe
Seminar jeweils donnerstags
19 Oktober bis 30 November
19 bis 21 Uhr
Kosten: 170 Franken pro Person/260 Franken pro Paar, Anmeldung bis am 13 Oktober; mindestens vier maximal zwölf
Teilnehmer Ort: Treffpunkt Falken, Falkenweg 10, 6340
Baar
Veranstalter: Liga Leben und Gesundheit Ortsgruppe
Baar www llg ch Telefon 041 508 12 57
Mit Christian Frei (Lebensberater) und Karin Rölli (Gesundheitsberaterin) pd
Leuchtende Kinderaugen. B d: pd Päckli

Wir suchen gut erhaltene Spielsachen (nicht grösser als 40 × 24 Zentimeter) Mützen Socken Handschuhe Süssigkeiten (haltbar bis 3/2024) Zahnpasta und -bürstli und so weiter für unsere Päckli-Aktion für Kinder in Moldawien Abgabe ab sofort in Kisten vor
Ort Oder kommen Sie zur Direktabgabe am 5 November ab 10 Uhr
Treffpunkt Falken Falkenweg
10 6340 Baar
ADRA-Ortsgruppe Baar Infos: adra ch, E Nigg: 078 667 10 67 (abends) Vielen herzlichen Dank für Ihre Unterstützung pd
Hier erhalten Sie Antworten rund ums Thema Tinnitus. Bi d pd
Kennen Sie es? Ein Pfeifen
Summen Brummen
Flimmern Dröhnen oder ein anderes lästiges Geräusch ertönt in Ihren Ohren Silvio Zgraggen Psychologe und Psychotherapeut aus Zug, erklärt uns, was Tinnitus ist und welche Erleichterungen es gibt um mit dieser Belas-
tung besser leben zu können Ihre Fragen sind erwünscht. Die Teilnahme ist kostenlos Wir freuen uns auf Sie! www pro-audito-zug ch pd
Tinn tus!? Was tun?

Samstag 21 Oktober
8 30 bis 11 30 Uhr
Pfarre he m St Mart n Baar
oder Premium Event online unter www.zugerpresse.ch

Sudoku leicht
Sudoku mittel
5 Unterschiede
Fü len Sie die Felder so aus, dass n jeder horizonta en und vert kalen Re he, aber auch in jedem der neun Quadrate, d e Zahlen von 1 bis 9 stehen Jede Zahl darf in jeder Reihe sowie in edem Quadrat nur einmal vorkommen
Schiffe suchen

Die Zahl am Ende jeder Zeile oder Spalte sagt Ihnen wie viele Felder durch Schiffe besetzt sind, wobei kein Sch ff ein anderes berührt - weder waagrecht noch senkrecht noch diagonal Jedes Sch ff ist von Wasser umgeben soweit es nicht den Rand des Spielfeldes berührt Suchen Sie: 4 x Ruderboot, 3 x Kutter, 2 x Yachten und 1 x Frachter
Preisrätsel: Kreuzworträtsel mit Gewinnspiel
Hier können Sie einen Migros-Gutschein gewinnen!


Möchten Sie einen Geschenkgutschein der Migros im Wert von 50 Franken gewinnen?

Senden Sie uns das richtige Lösungswort per Mail an: redaktion-zugerpresse@chmedia ch
Betreff: Kreuzworträtsel
Teilnahmeschluss ist jeweils am Montag der Folgewoche um 15 Uhr
Die Gewinner werden schriftlich benachrichtigt
Auflösungen von dieser Seite
Online Video-Studio aufrufen 3 Video-Sequenzen mit deinem Smartphone aufnehmen Fixfertig produziertes Video deiner Bewerbung hinzufügen

QR-CODE SCANNENUND LOSLEGEN

